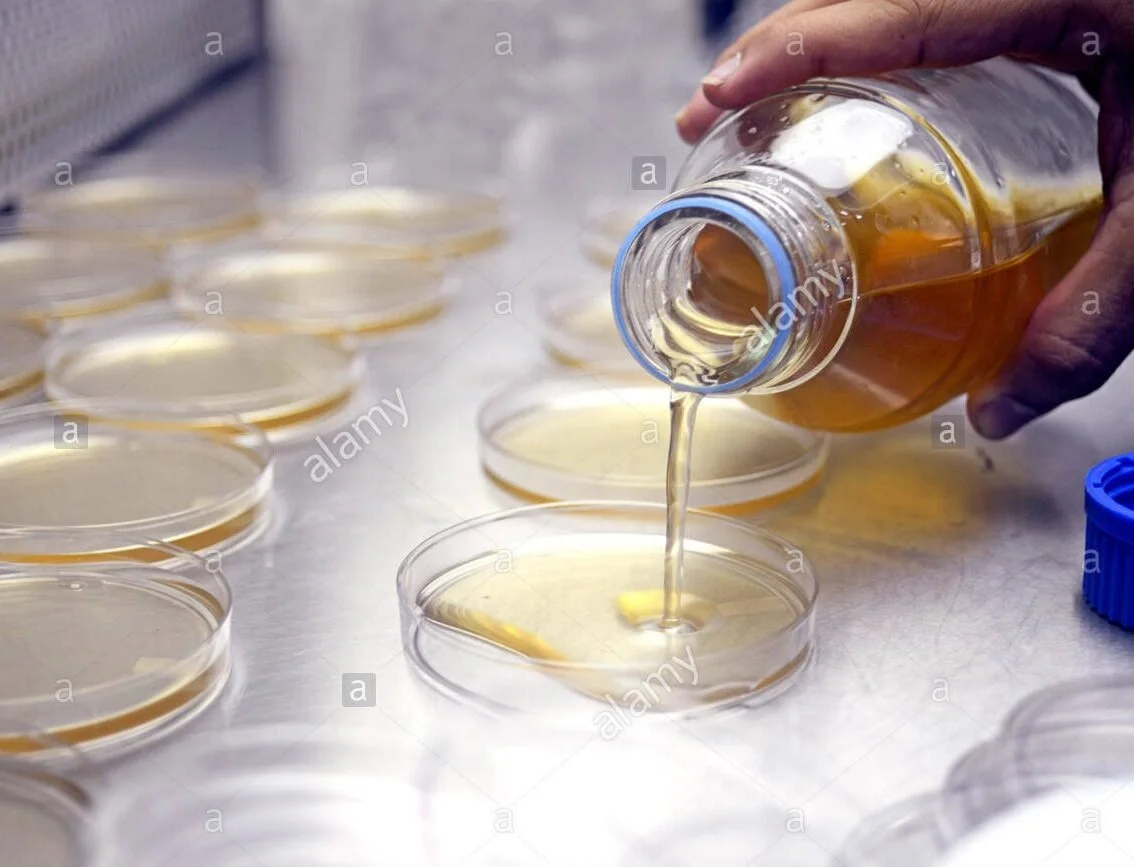

-
Our journey and unique roots
Our partnerships that help us explore the best solutions for Wound Care, better for the animals, better for the planet.
With 30 years of experience as an equine veterinarian, Dr. Tim Montgomery, BVMS, is passionate about animal health and wellbeing. Through firsthand experience in realizing the effectiveness of Mānuka in treating animal wounds, Tim was motivated to share this knowledge with peers and the wider veterinary industry.
It’s this motivation that led Tim to partner with Oha Honey, innovators of Mānuka Honey, and operators of one the largest apiaries in New Zealand. Oha Honey’s strong supply chain and dedication to extend their capabilities into the animal health market gives this partnership the commercial scalability required to achieve global reach.
Together, with technical expertise across veterinary care and Mānuka, they developed DermelVet, a science-led product that helps animals return to performance, faster.
We are proud to share this clinically proven, independently tested product, globally.